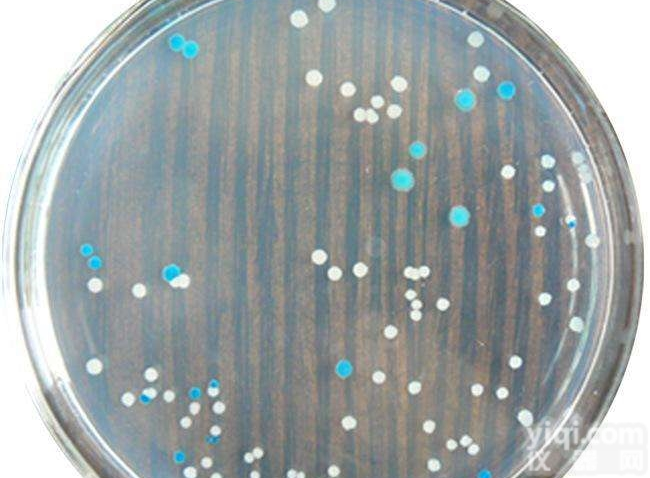
MM培养基<em>维生素</em>溶液<em>说明书</em>

人25羟基维生素D(25-OH-VD)说明书
- 产地:上海
- 供应商:武汉友联特生物技术有限公司
- 供应商报价:面议
- 标签:人25羟基维生素D(25-OH-VD)说明书,1,武汉友联特生物技术有限公司
人25羟基维生素D(25-OH-VD)说明书试验原理:
人Giα-2 ELISA试剂盒是固相夹心法酶联免疫吸附实验(ELISA).已知待测物质浓度的标准品、未知浓度的样品加入微孔酶标板内进行检测。先将待测物质和生物素标记的抗体同时温育。洗涤后,加入亲和素标记过的HRP。再经过温育和洗涤,去除未结合的酶结合物,然后加入底物A、B,和酶结合物同时作用。产生颜色。颜色的深浅和样品中待测物质的浓度呈比例关系。
人25羟基维生素D(25-OH-VD)说明书内容及其配制
人25羟基维生素D(25-OH-VD)说明书自备材料
1)蒸馏水。
2)加样器:5ul、10ul、50ul、100ul、200ul、500ul、1000ul。
3)振荡器及磁力搅拌器等。
1)避免直接接触终止液和底物A、B。一旦接触到这些液体,请尽快用水冲洗。
2)实验中不要吃喝、抽烟或使用化妆品。
3)不要用嘴吸取试剂盒里的任何成份。
人25羟基维生素D(25-OH-VD)说明书操作注意事项
1)试剂应按标签说明书储存,使用前恢复到室温。稀稀过后的标准品应丢弃,不可保存。
2)实验中不用的板条应立即放回包装袋中,密封保存,以免变质。
3)不用的其它试剂应包装好或盖好。不同批号的试剂不要混用。保质前使用。
4)使用一次性的吸头以免交叉污染,吸取终止液和底物A、B液时,避免使用带金属部分的加样器。
5)使用干净的塑料容器配置洗涤液。使用前充分混匀试剂盒里的各种成份及样品。
6)洗涤酶标板时应充分拍干,不要将吸水纸直接放入酶标反应孔中吸水。
7)底物A应挥发,避免长时间打开盖子。底物B对光敏感,避免长时间暴露于光下。避免用手接触,有毒。实验完成后应立即读取OD值。
8)加入试剂的顺序应一致,以保证所有反应板孔温育的时间一样。
9)按照说明书中标明的时间、加液的量及顺序进行温育操作。
金属蛋白酶2/明胶酶A(MMP-2/Gelatinase A)ELISA试剂盒 Human Matrix metalloproteinase 2/Gelatinase A,MMP-2 Elisa试剂盒
人基质金属蛋白酶13(MMP-13)ELISA试剂盒 Human Matrix metalloproteinase 13,MMP-13 Elisa试剂盒
人基质金属蛋白酶10(MMP-10)ELISA试剂盒 Human Matrix metalloproteinase 10,MMP-10 Elisa试剂盒
人基质金属蛋白酶1(MMP-1)ELISA试剂盒 Human Matrix metalloproteinase 1,MMP-1 Elisa试剂盒 Acetyl CoA Carboxylase代测厂家乙酰辅酶A羧化酶抗体
Phospho-Acetyl Coenzyme A carboxylase alpha (Ser78)代测厂家磷酸化乙酰辅酶A羧化酶抗体
Phospho-Ack1 (Tyr859 + 860)代测厂家磷酸化Ack1抗体
phospho-AMPK alpha-1(Ser485+Ser491)代测厂家磷酸化腺苷单磷酸活化蛋白激酶α1抗体

![3-[ (1,1-二甲基-2-<em>羟基</em>乙基)氨基]-2-<em>羟基</em>丙磺酸钠<em>说明书</em>](https://item.yiqi.com/pic/CovPic/3/201606070145133040.jpg)

![3-[(3-胆固醇氨丙基)二甲基氨基]-2-<em>羟基</em>-1-丙磺酸<em>说明书</em>](https://item.yiqi.com/pic/CovPic/3/201606121130383840.jpg)







